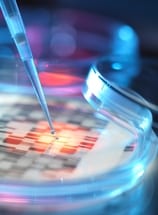

Lowe Syndrome
Lowe syndrome is a rare genetic condition that affects males more often than females. It is sometimes referred to as oculo-cerebro-renal syndrome of Lowe (OCRL) because it affects the eyes, brain and kidneys. Lowe syndrome is named after Dr. Charles Lowe, the senior member of a group of colleagues that initially described this condition. Symptoms of Lowe syndrome include developmental delays, vision problems and kidney abnormalities. Lowe syndrome is an inherited condition caused by a defective gene.
Lowe syndrome is a rare genetic condition that affects males more often than females. It is sometimes referred to as oculo-cerebro-renal syndrome of Lowe (OCRL) because it affects the eyes, brain and kidneys. Lowe syndrome is named after Dr. Charles Lowe, the senior member of a group of colleagues that initially described this condition. Symptoms of Lowe syndrome include developmental delays, vision problems and kidney abnormalities. Lowe syndrome is an inherited condition caused by a defective gene.
Symptoms of Lowe Syndrome
Infants born with Lowe syndrome have congenital cataracts, a thick clouding that covers the lenses of both eyes. Other eye abnormalities or vision problems may also exist, including infantile glaucoma, which causes increased pressure within the eyes. Additional symptoms of Lowe syndrome may include:
- Muscle weakness
- Intellectual impairment
- Impaired growth
- Developmental disabilities
- Behavioral problems
Kidney abnormalities, most commonly a condition known as renal Fanconi syndrome, are also symptoms of Lowe syndrome. Kidney problems may lead to dehydration, increased urination and abnormal amounts of acidity in the blood. Rickets may also develop.
Diagnosis of Lowe Syndrome
If Lowe syndrome is suspected in a child, blood and skin samples may be taken and sent for genetic DNA testing to confirm a diagnosis. Prenatal genetic testing may also be performed to confirm a diagnosis of the fetus prior to birth.
Treatment of Lowe Syndrome
There is no cure for Lowe syndrome and treatment focuses on managing symptoms. Medication is prescribed to treat kidney problems and phosphates and vitamin D may be given to treat or prevent rickets. Surgery may be performed to remove cataracts. Mental and physical disabilities may be addressed with a combination of physical and occupational therapies, vision therapy and special education. Nutritionists may also be consulted regarding appropriate food choices and diets for this condition.



